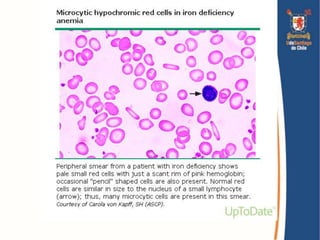
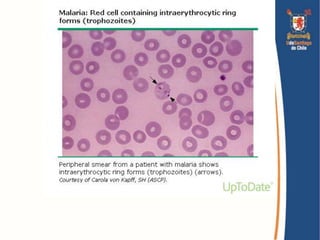

El documento presenta una introducción al acercamiento diagnóstico del paciente con anemia. Explica la definición de anemia y los criterios de la OMS. Describe la función de los glóbulos rojos, la eritropoyesis, los mecanismos de adaptación y las manifestaciones clínicas de la anemia. Además, introduce las clasificaciones morfológica y fisiopatológica de las anemias y los enfoques para la evaluación y diagnóstico diferencial del paciente con anemia.